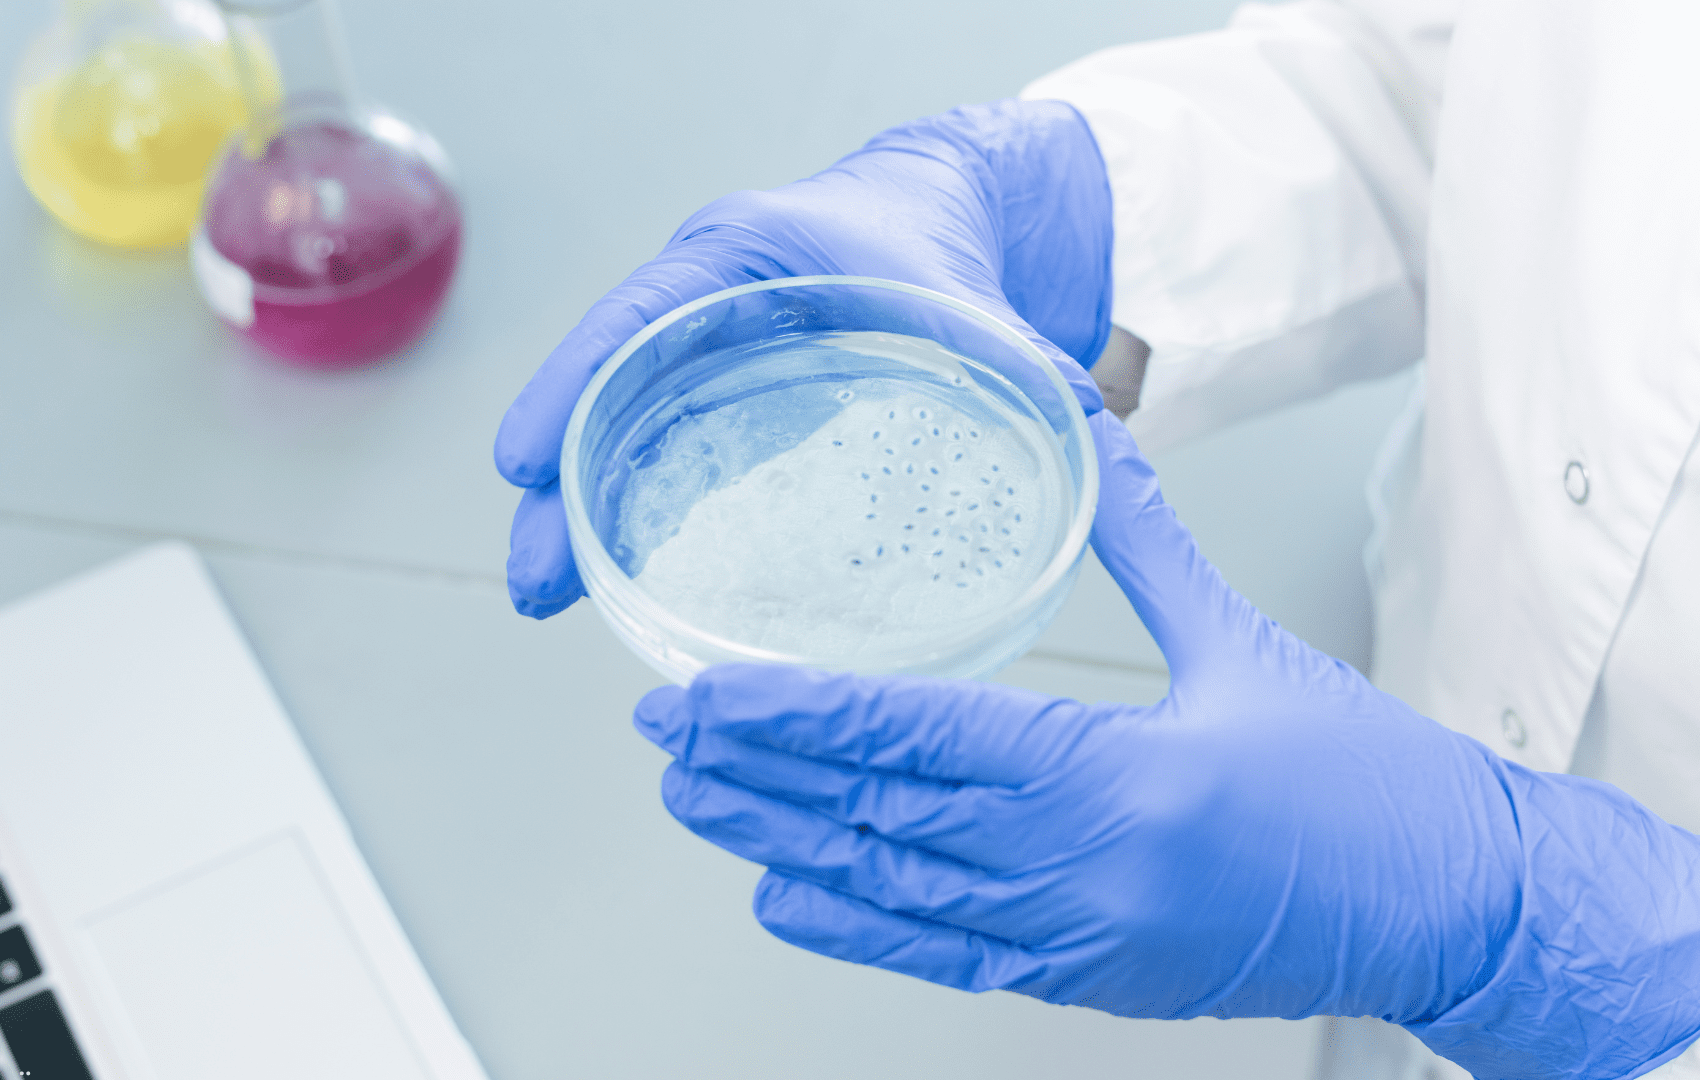

Criopreservação MEDY: nova técnica capaz de manter estrutura do tecido cerebral

Você já ouviu falar na criopreservação MEDY? Segundo um artigo publicado na Cell Reports Methods no ano passado, essa nova técnica é capaz de realizar a criopreservação de tecido cerebral e organoides.
[lwptoc colorScheme="inherit" borderColor="#fcfcfc"]
A criopreservação ainda é um desafio no estudo de tecido cerebral
Para estudar doenças neurológicas humanas, modelos de tecido cerebral humano são essenciais, assim como estruturas chamadas de organoides (células-tronco embrionárias humanas para cultivar amostras cerebrais auto-organizadas).
Esses mecanismos devem ser capazes de suportar os processos de congelamento e descongelamento. Entretanto, o principal problema é que o tecido cerebral geralmente não sobrevive ao descongelamento, pois fica com sua estrutura muito alterada.
Com isso em mente, pesquisadores avaliaram uma nova forma de criopreservação – a chamada criopreservação MEDY.

Organoides cerebrais são uma opção para o estudo de doenças neurológicas
Os custos humanos e financeiros impostos pelas doenças cerebrais são extremamente altos. Mais de 90% dos novos medicamentos candidatos para essas doenças falham durante os ensaios clínicos, sendo que uma das principais dificuldades é traduzir os resultados de modelos animais para humanos.
Nos últimos anos, a tecnologia de organoides tem sido um dos avanços mais importantes no campo da pesquisa biomédica. Com a melhoria dessa tecnologia, os organoides cerebrais têm mostrado grande potencial para estudar o desenvolvimento do cérebro humano, entender doenças cerebrais e desenvolver novos medicamentos.
Os organoides cerebrais são estruturas complexas construídas por várias células neurais em cultura e mostram função neural e atividade de rede, demonstrando grande potencial para explorar doenças cerebrais humanas. No entanto, as restrições dos organoides cerebrais, como a necessidade de cultura a longo prazo, altos custos e problemas de armazenamento, limitam significativamente sua aplicação em estudos biomédicos.
O tecido cerebral humano fresco e viável, com características patológicas naturais, é um modelo mais confiável para estudar doenças neurológicas. Entretanto, com acessibilidade e manipulabilidade limitadas, a criopreservação e a reconstrução do tecido cerebral vivo com características patológicas específicas permanecem desafios enormes, pois é difícil manter a sobrevivência de grandes quantidades de neurônios funcionais.
Portanto, é essencial desenvolver uma tecnologia de criopreservação confiável para tecido cerebral humano fresco e para organoides cerebrais, que possam ser utilizados para estudar os mecanismos patológicos das doenças cerebrais, transplante de organoides para lesões cerebrais e/ou descoberta de medicamentos.
Importância da criopreservação cerebral
Atualmente, a tecnologia de criopreservação tem sido demonstrada para células-tronco embrionárias, gametas, embriões, organoides de glioblastoma, órgãos do endométrio etc. As primeiras demonstrações de criopreservação mostraram que o esperma bovino poderia ser congelado, descongelado e fertilizado com sucesso in vitro, resultando em bezerros.
Tanto os organoides de glioblastoma quanto os organoides de endométrio têm uma forte capacidade de proliferação e regeneração, o que pode amplificar a sobrevivência das células após a criopreservação e incentivar a recuperação das células. No entanto, devido às limitações na renovação de sua estrutura, a criopreservação de organoides cerebrais com citoarquitetura complexa não foi demonstrada. Portanto, os métodos de congelamento disponíveis para células bidimensionais (2D) e organoides não neurais são inadequados para organoides neurais e tecido cerebral humano vivo.

Como é o método de criopreservação MEDY?
Neste estudo recente, publicado na Cell Reports Methods, foi estabelecido um novo método de criopreservação usando um novo meio com metilcelulose, etilenoglicol, DMSO e Y27632 (denominado MEDY) para a criopreservação de organoides corticais grandes e cultivados a longo prazo, sem perturbar a população de células neurais, a citoarquitetura ou a atividade funcional.
Além disso, a criopreservação MEDY pode ser aplicada para múltiplos organoides específicos de regiões cerebrais, incluindo o prosencéfalo dorsal e ventral, a medula espinhal, o cérebro da vesícula óptica e os organoides cerebrais derivados de pacientes com epilepsia. Por fim, o MEDY pode ser utilizado para a criopreservação de tecido cerebral humano, mantendo características patológicas.
Com esse estudo, cai significativamente o tempo de preparação e o custo dos organoides neurais, além de ser possível a manutenção do tecido cerebral humano vivo para promover pesquisas básicas, aplicações médicas e triagem de medicamentos.

Entenda mais sobre o estudo
Os pesquisadores colocaram esses organoides em diferentes substâncias (como açúcares e descongelantes), para testar em qual meio os organoides manteriam sua estrutura. Em seguida, os organoides foram congelados em nitrogênio líquido por pelo menos 24 horas. Por fim, os pesquisadores os descongelaram e procuraram por sinais de morte celular pelas duas semanas seguintes.
Para descobrir a composição ideal para realizar a criopreservação, os autores analisaram os sinais de morte e de crescimento celular nessas substâncias, assim como realizaram combinações entre elas. Por fim, chegaram na composição do MEDY.
Mesmo nos organoides que foram congelados por até 18 meses, os pesquisadores observaram que a aparência, crescimento e função dos organoides descongelados era igual a organoides da mesma idade que nunca haviam sido congelados.
Os autores também retiraram cubos de 3 milímetros de tecido cerebral de uma menina de 9 meses com epilepsia e os colocaram no MEDY. Após o descongelamento, foi observado que o tecido manteve sua estrutura e continuou ativo em cultura.

O maior desafio na criopreservação de organoides cerebrais 3D é evitar ou reduzir a formação de cristais de gelo. Os pesquisadores testaram componentes como trealose, prolina, sacarose e glicose. Entretanto, aditivos como metilcelulose, PVP e etilenoglicol foram os únicos que cumpriram um papel protetor para os organoides cerebrais durante o processo de criopreservação.
A metilcelulose, que engrossa a atividade da superfície, formando um filme e um gel quente, contribui para a sobrevivência dos organoides descongelados. Combinar metilcelulose com PVP e etilenoglicol pode melhorar ainda mais os efeitos protetores.
Os pesquisadores descobriram que o MEDY pode proteger organoides cerebrais durante a criopreservação, inibindo as vias apoptóticas controladas pelo retículo endoplasmático e promovendo a expressão de genes envolvidos no desenvolvimento neural e na função sináptica. No entanto, o mecanismo molecular da resposta ao MEDY antes do congelamento e após o descongelamento e os papéis exatos de cada componente do MEDY ainda precisam ser explorados.
Neste estudo, embora a tecnologia de criopreservação MEDY pudesse manter a diversidade celular, a estrutura funcional e até a atividade da rede neural dos organoides cerebrais, é realmente desafiador preservar o mesmo estágio de desenvolvimento dos organoides neurais após o congelamento.

Vantagens da neuropreservação MEDY
Atualmente, os testes de medicamentos pré-clínicos ainda utilizam principalmente modelos animais, o que provavelmente contribui para a frequente falha dos ensaios clínicos. Doenças cerebrais, como esquizofrenia, lesões do sistema nervoso central e doenças neurodegenerativas ainda carecem de estratégias de tratamento eficazes devido aos seus mecanismos pouco claros no cérebro humano.
Para lesões do sistema nervoso central, como lesão da medula espinhal, a tecnologia de criopreservação MEDY pode manter organoides terapêuticos da medula espinhal para potencial transplante.
Organoides derivados de um grande número de pacientes podem ser usados para construir um biobanco de organoides personalizados para o desenvolvimento da medicina de precisão no futuro. A criopreservação em larga escala de organoides diminuiria os custos associados ao estudo de organoides e aceleraria a pesquisa biomédica.
A criopreservação MEDY pode preservar as características patológicas do tecido cerebral humano fresco em grandes tamanhos (2-3 mm), enquanto estudos anteriores relataram que o tecido cerebral vivo só poderia ser cultivado na forma de fatias com espessura abaixo de 1 mm. O tecido cerebral de pacientes criopreservado com MEDY poderia ser mantido como estruturas maiores e usado em pesquisas para diversos propósitos a qualquer momento após a coleta das amostras, apoiando a preservação a longo prazo e a utilização eficaz de amostras clínicas importantes. A criopreservação MEDY oferece uma nova tecnologia simples para a biopreservação de tecido cerebral vivo.

Conclusão
O método de criopreservação MEDY permite a criopreservação de amostras de tecido cerebral humano, sendo que características patológicas são mantidas após o descongelamento.
A análise transcriptômica mostra que o MEDY pode proteger a função sináptica e inibir a via de apoptose mediada pelo retículo endoplasmático. Com essa técnica, será possível o armazenamento em larga escala e de forma confiável de diversos organoides neurais e tecido cerebral vivo, facilitando pesquisas abrangentes, aplicações médicas e triagem de medicamentos.
De acordo com João Pedro Magalhães, da Universidade de Birmingham, “Pensando décadas ou séculos à frente, podemos imaginar pacientes sendo criopreservados quando apresentam uma condição terminal ou astronautas sendo criopreservados para viajar para outros sistemas estelares”.
--
Referências:
XUE, W. et al. Effective cryopreservation of human brain tissue and neural organoids. Cell reports methods, V. 4, n. 5, 100777, MAY 20, 2024. https://doi.org/10.1016/j.crmeth.2024.100777.
NEWS MED. Tecido cerebral humano congelado agora pode ser revivido sem danos. 2024. https://www.news.med.br/p/medical-journal/1469792/tecido-cerebral-humano-congelado-agora-pode-ser-revivido-sem-danos.htm. Acesso em 17 de junho de 2024.





